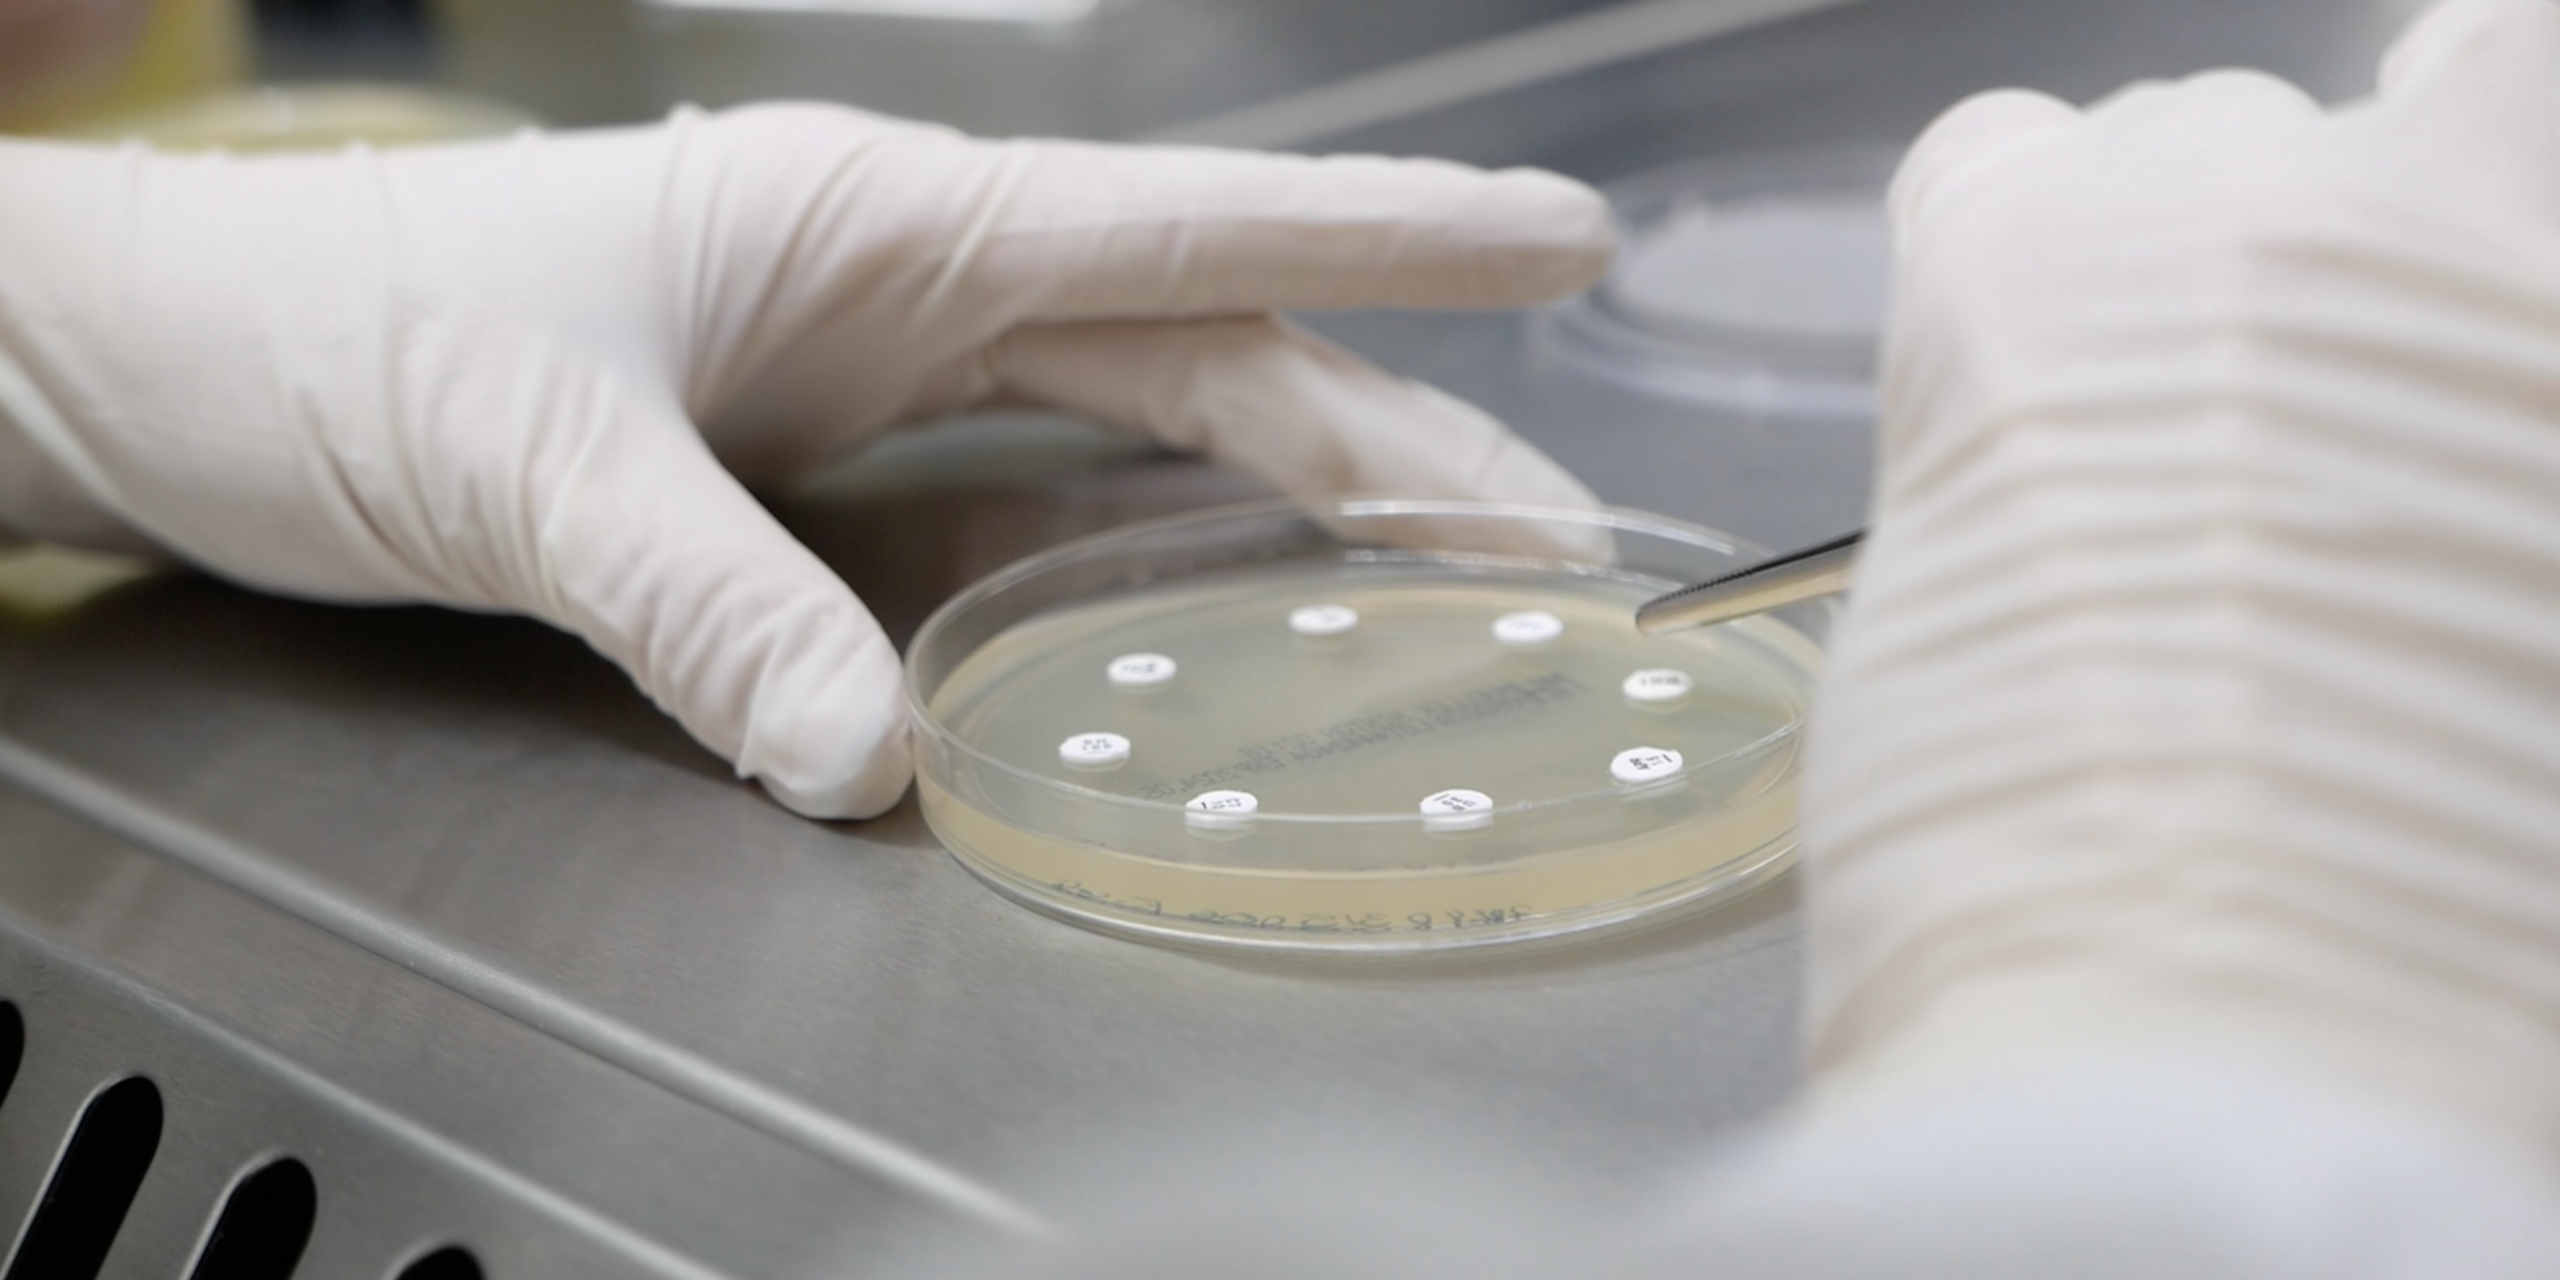

En el día a día del laboratorio vemos cómo un antibiograma marca la diferencia en la gestión de la salud animal.
Gracias a esta herramienta, podemos ajustar el tratamiento con precisión, respondiendo de forma eficaz a cada caso y evitando terapias que no aportan beneficios reales.
Trabajamos para ofrecer resultados rápidos y fiables, conscientes de que son esenciales para frenar la aparición de resistencias y mejorar el rendimiento productivo. Un antibiograma bien interpretado no solo optimiza el uso de antimicrobianos, sino que también proporciona una base sólida para tomar decisiones rápidas y fundamentadas.
En Zenit seguimos apostando por un diagnóstico microbiológico riguroso que acompañe al veterinario en cada paso. Nuestro objetivo es el mismo: proteger la salud animal con información clara, útil y técnicamente robusta.